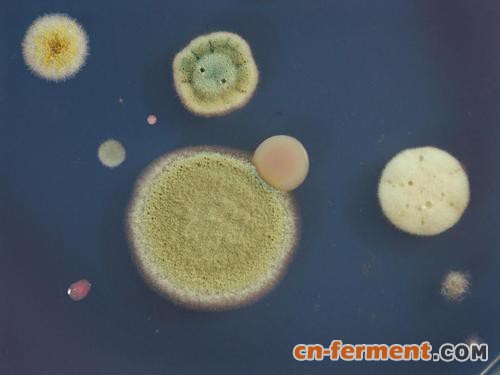
Berkeley Lights和Amyris合作改进微生物菌株的检测

合作的目标是实施Beacon平台,以识别和分离产生最高量非治疗产品的微生物菌株。Beacon平台目前用于通过将先前分散的宏观流体工作流转换为自动纳米流体工作流来压缩时间线并提高药物发现和开发的能力。最初的概念验证表明,Beacon平台有可能将Amyris的应变测试能力提高十倍,从而增加容量并进一步提高Amyris产品开发的速度。Beacon平台与Amyris经过验证的商业规模多种产品的能力之间的协同作用,有能力进一步提高可持续再生产品的可用性。
Beacon平台是我们见过的为数不多的技术之一,它可以在很短的时间内以前所未有的规模测试工程微生物菌株,为合成生物学提供真正先进的解决方案。与伯克利灯光的合作预计不仅会增加我们对高价值商业资产的筛选能力,而且还会以总成本的一小部分提供高产量的应变。这将有助于以更低的成本支持商业规模产品的上市速度。“
在Berkeley Lights,我们的使命是加速客户的产品开发周期。我们的目标是使像Amyris这样的合作伙伴能够大大缩短其小分子管道中关键资产的上市时间,Amyris是生物制造领域的早期先驱和现任领导者。通过应用我们的工作流程,以提高工艺产量和缩短交付周期,我们可以快速帮助我们的合作伙伴实现可扩展和可持续的制造,涵盖各种生物基产品。此外,鉴于Amyris已证明能够在多种产品上进行商业扩展,我们认为Beacon具有积极的商业影响力。“













